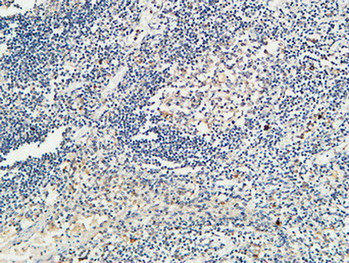
14 - KiSS-1R Polyclonal Antibody AP70663

KiSS-1R Polyclonal Antibody
- 产品详情
- 实验流程
- 背景知识
Application
| IHC-P, IF, ICC, E |
|---|---|
| Primary Accession | Q969F8 |
| Reactivity | Human, Rat, Mouse |
| Host | Rabbit |
| Clonality | Polyclonal |
| Calculated MW | 42586 Da |
| Gene ID | 84634 |
|---|---|
| Other Names | KISS1R; AXOR12; GPR54; KiSS-1 receptor; KiSS-1R; G-protein coupled receptor 54; G-protein coupled receptor OT7T175; hOT7T175; Hypogonadotropin-1; Kisspeptins receptor; Metastin receptor |
| Dilution | IHC-P~~Immunofluorescence: 1/200 - 1/1000. ELISA: 1/5000. Not yet tested in other applications. IF~~Immunofluorescence: 1/200 - 1/1000. ELISA: 1/5000. Not yet tested in other applications. ICC~~N/A E~~N/A |
| Format | Liquid in PBS containing 50% glycerol, 0.5% BSA and 0.09% (W/V) sodium azide. |
| Storage Conditions | -20℃ |
| Name | KISS1R |
|---|---|
| Synonyms | AXOR12 {ECO:0000303|PubMed:11387329}, GP |
| Function | Receptor for kisspeptins (kisspeptin-10, kisspeptin-13, kisspeptin-14 and metastin/kisspeptin-54) (PubMed:11457843, PubMed:11527393, PubMed:15020672, PubMed:15596153). The hypothalamic KISS1/KISS1R signaling system plays a central role in the regulation of the hypothalamic-pituitary-gonadal reproductive axis by modulating the secretion of gonadotropin-releasing hormone (GnRH) from GnRH neurons (PubMed:12944565, PubMed:14573733, PubMed:15598687, PubMed:17164310, PubMed:18272894). In these neurons, kisspeptin binding to its receptor activates G(q)-dependent signaling, leading to phospholipase C (PLC) activation, and hydrolysis of phosphatidylinositol 4,5-bisphosphate (PIP2) (PubMed:14573733, PubMed:15598687, PubMed:39151001). The subsequent rise in intracellular calcium levels results in the inhibition of inward rectifier potassium channels and activation of TRPC-like cation channels, leading to GnRH neurons depolarization and stimulation (By similarity). In addition to this pathway, kisspeptin also triggers G(q)-independent signaling via beta-arrestin, leading to MAPK cascade activation and ERK1/ERK2 phosphorylation (PubMed:25147978). Furthermore, activation of KISS1R by kisspeptin-10 recruits phosphatase DUSP18 and SRC to the KISS1R C-terminus through a G(q)-dependent signaling pathway, leading to DUSP18-mediated dephosphorylation of SRC (PubMed:38346942). In bone tissue, this results in down-regulation of osteoclast differentiation and activity, and consequently suppression of bone resorption (By similarity). KISS1R is also involved in the regulation of other processes, including cell proliferation and cell migration (PubMed:11457843, PubMed:11527393, PubMed:15020672, PubMed:15596153, PubMed:38512807). |
| Cellular Location | Cell membrane; Multi-pass membrane protein |
| Tissue Location | Expressed in the pancreas, placenta and spinal cord, with lower-level of expression in peripheral blood leukocytes, kidney, lung, fetal liver, stomach, small intestine, testes, spleen, thymus, adrenal glands and lymph nodes. In the adult brain, expressed in the superior frontal gyrus, putamen, caudate nucleus, cingulate gyrus, nucleus accumbens, hippocampus, pons and amygdala, as well as the hypothalamus and pituitary. Expression levels are higher in early (7-9 weeks) than term placentas. Expression levels were increased in both early placentas and molar pregnancies and were reduced in choriocarcinoma cells. Expressed at higher levels in first trimester trophoblasts than at term of gestation. Also found in the extravillous trophoblast suggesting endocrine/paracrine activation mechanism |
For Research Use Only. Not For Use In Diagnostic Procedures.
Provided below are standard protocols that you may find useful for product applications.
BACKGROUND
Receptor for metastin (kisspeptin-54 or kp-54), a C- terminally amidated peptide of KiSS1. KiSS1 is a metastasis suppressor protein that suppresses metastases in malignant melanomas and in some breast carcinomas without affecting tumorigenicity. The metastasis suppressor properties may be mediated in part by cell cycle arrest and induction of apoptosis in malignant cells. The receptor is essential for normal gonadotropin-released hormone physiology and for puberty. The hypothalamic KiSS1/KISS1R system is a pivotal factor in central regulation of the gonadotropic axis at puberty and in adulthood. The receptor is also probably involved in the regulation and fine- tuning of trophoblast invasion generated by the trophoblast itself. Analysis of the transduction pathways activated by the receptor identifies coupling to phospholipase C and intracellular calcium release through pertussis toxin-insensitive G(q) proteins.
终于等到您。ABCEPTA(百远生物)抗体产品。
点击下方“我要评价 ”按钮提交您的反馈信息,您的反馈和评价是我们最宝贵的财富之一,
我们将在1-3个工作日内处理您的反馈信息。
如有疑问,联系:0512-88856768 tech-china@abcepta.com.























 癌症的基本特征包括细胞增殖、血管生成、迁移、凋亡逃避机制和细胞永生等。找到癌症发生过程中这些通路的关键标记物和对应的抗体用于检测至关重要。
癌症的基本特征包括细胞增殖、血管生成、迁移、凋亡逃避机制和细胞永生等。找到癌症发生过程中这些通路的关键标记物和对应的抗体用于检测至关重要。 为您推荐一个泛素化位点预测神器——泛素化分析工具,可以为您的蛋白的泛素化位点作出预测和评分。
为您推荐一个泛素化位点预测神器——泛素化分析工具,可以为您的蛋白的泛素化位点作出预测和评分。 细胞自噬受体图形绘图工具为你的蛋白的细胞受体结合位点作出预测和评分,识别结合到自噬通路中的蛋白是非常重要的,便于让我们理解自噬在正常生理、病理过程中的作用,如发育、细胞分化、神经退化性疾病、压力条件下、感染和癌症。
细胞自噬受体图形绘图工具为你的蛋白的细胞受体结合位点作出预测和评分,识别结合到自噬通路中的蛋白是非常重要的,便于让我们理解自噬在正常生理、病理过程中的作用,如发育、细胞分化、神经退化性疾病、压力条件下、感染和癌症。